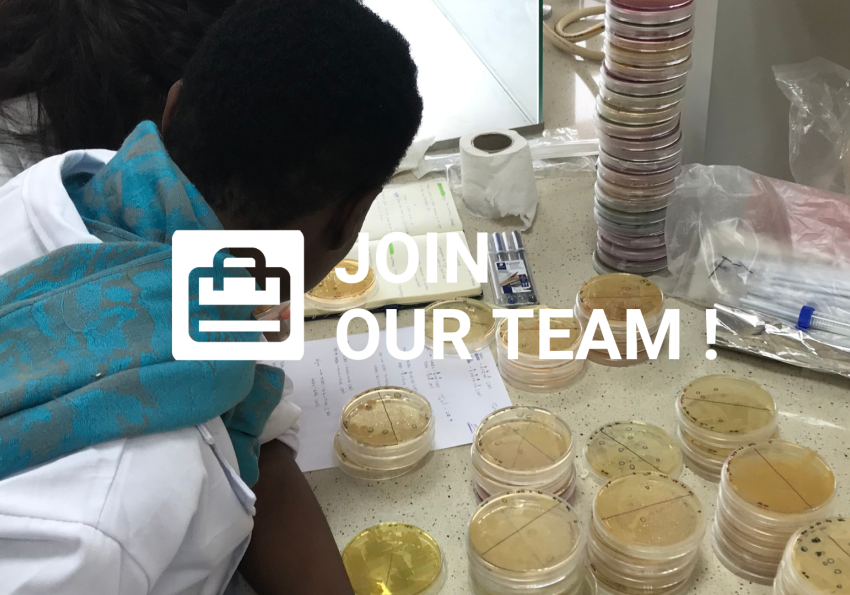
join

CCMAR/BINCGAM/03/2025 | Research Fellowship (M/F) | Biological Sciences | 1 Vacancy
Research Fellowship – 1 Vacancy
Within the project – 541666287
HealthyBi4Namibe
Ref. ª: CCMAR/BINCGAM/03/2025
The Centre for Marine Sciences (CCMAR) opens one (01) Research Fellowship (BI) for a person with a Master Degree (Bolsa de Investigação não conducente à obtenção de grau académico para mestre), of any nationality, including stateless candidates, and holders of political refugee statute, in the scientific field of Biological Sciences within the research project: HealthyBi4Namibe – “Development of technological tools to improve and reduce health risks for bivalve consumption in Angola” funded by the Aga Khan, Network for Development and the Portuguese Foundation for Science and Technology, I.P/MCTES under the following conditions:
Host and Contracting Institution: CCMAR
This fellowship is intended for master’s degree holders that are enrolled in a non-academic degree course, integrated in the educational project of a higher education institution, and developed in association or cooperation with one or more R&D units at the starting date of the fellowship.
Work Plan, Tasks to perform and objectives:
The HealthyBi4Namibe project aims to study and characterize the impact of environmental threats (pathogens, toxic blooms, and environmental pollutants) on marine bivalves to develop and implement technologies to assess and ameliorate their quality and safety risk for human consumption in Namibe (Angola).
The fellowship holder will work under the supervision and guidance of the supervisors. Training will be provided, and the plan will be developed to contribute to finalize pending tasks within WP1- Characterize the impact of the environment in marine bivalves and WP2- Identify bivalve responsive genes to environmental challenges. Specifically, within task 1.1 Microbiome and task 2.1 Experimental challenges and Transcriptome.
Detailed work plan:
a) Handling, analysis and interpretation of microbiome, transcriptome and metagenome data;
b) Extraction of RNA/DNA from bivalve and environmental samples and perform molecular and expression analysis (PCR and q-PCR) of target gene family candidates in bivalve tissues;
c) Develop PCRs for detection of microbial pathogens in bivalves and environmental samples;
d) Contribute to scientific paper writing and supervision of undergraduate students and general laboratory organization and daily routines;
e) Attend international conferences with oral/poster communications;
f) Contribute to the organization of project final workshop and preparation of the e-book.
Scientific Supervisors:Professor Doctor João Cardoso, Professor at the Algarve University, researcher at CCMAR and coordinator of the project and Professor Deborah Power, Full Professor at Algarve University and group leader at CCMAR.
Work place: The workplace is CCMAR (Gambelas Campus of the Algarve University, Faro, Portugal) and other places necessary for the competition of the work plan.
Requirements for the application:
Applicants must meet all the conditions stated below:
Master’s degree in Biotechnology, Molecular Biology, Aquaculture or related fields.
Good knowledge of written and spoken English.
Experience in Molecular Biology techniques for extraction of RNA and DNA and gene amplification (PCR and qPCR) from marine environmental samples
Experience on the usage of bioinformatic tools applied to the analysis of transcriptomes and metagenomes of bivalve and marine environmental samples.
Availability to travel to, and work for short periods (up to 1 months) in Namibe (Angola)
This fellowship will only be granted to those who do not exceed, with the conclusion of the present fellowship contract, an accumulated period of two years in this type of fellowship, consecutive or otherwise, and this information should be explicitly stated in the candidate’s CV.
Non-compliance justifies exclusion from the procedure.
It is considered as an advantage:
Preference will be given to applicants clearly demonstrating they have experience in working with bivalves and in aquaculture.
Evaluation criteria:
Through the analysis of the application documents the evaluation criteria for the applications and their relative weight for ranking are as follows:
Master academic degree grade - 35%;
Proven experience in molecular biology techniques for nucleic acid analysis extraction and amplification – 20%;
Proven experience on the usage of bioinformatic tools applied to transcriptomes and metagenomes – 30 %;
Published scientific articles or scientific presentations in the field of knowledge - 15%;
The selection committee reserves the right to contact and interview candidates if additional information or clarification of any curricular aspect is necessary. In case it takes place, the interview aims to evaluate in more detail the curricular items used to grade the candidate according to the list above.
In the event that no applicant has the necessary profile, the selection committee reserves the right to close the call without any recruitment. In the event that the selected person does not take up the position because of failure to comply with documentary requirements or any other reason, or later during the contract if they resign, the jury reserves the right, upon convenience and opportunity, to assign the post to the next applicant in accordance with the ranking positions based on the selectable reservation list that can be used up to 12 months of the date of the present announcement.
Fellowship conditions: The fellowship will have a duration of 7 months, eventually renewed for additional periods with a total maximum of 12 months or until the end of the project, with a provisional start date of March 2025. The fellowship must be carried out full-time (exclusive regime), according to the FCT Fellowship Rules (RBI) and the CCMAR fellowship rules (see here), which are based on the Portuguese law 40/2004, of 18 of August (Scientific Research Fellowship holder statutes) amended by the Decree-Law 123/2019 of 28 of August. A maintenance allowance of 1309.64€ will be paid monthly, through bank transfer, and will be updated as stipulated by the Foundation for Science and Technology (see here https://bit.ly/2ZcxUGJ).
Application period: from 21th of February 2025 to 6th of March 2025 at 23:59 (Lisbon time, Portugal).
Application process and mandatory documents:
Complete applications must be submitted online at https://ccmar.ualg.pt/en/career-opportunities and must include:
A motivation letter (in English);
A detailed Curriculum Vitae (in English);
A copy of the Master degree Certificate with the final classification;
The email contact of up to 3 referees.
Non-compliance with this documents/information determines the immediate rejection of the application.
Results and Preliminary Hearing: The admission and evaluation results will be communicated by email within 90 working days after the application deadline. After notification, candidates have 10 working days to contest the preliminary decision.
Selection Committee: Professor João Cardoso, Professor at the Algarve University, researcher at CCMAR and coordinator of the project (President of the jury); Professor Deborah Power, Full Professor at Algarve University and group leader at CCMAR (member of the jury) and Professor Adelino Canário, President of the CCMAR Board of Directors (member of the jury), Doctor Teresa Correia, Researcher and CCMAR member (Substitute member) and Doctor Zélia Velez, Researcher at CCMAR (Substitute member).
Notes:
Hiring Documents
After the candidate is selected and for the hiring purpose the following documentation/information will be requested:
- Proof of the enrolment (Certidão de inscrição/matricula) from the Academic Services in a non-academic degree course (in accordance with the declaration on honour).
-Copy of the certificate of the Master’s degree;
- Declaration of commitment stating the exclusivity regime.
- Civil, fiscal and social security Identification (if applicable)
- Account Number – IBAN
- Ciência ID: https://www.ciencia-id.pt/CienciaID/HomePage.aspx
- If applicable, a statement from the candidate saying that does not exceed, with the conclusion of the present fellowship contract, an accumulated period of two years in this type of fellowship, consecutive or otherwise.
Fellowship Agreement model
After the candidate selection and all information is received, it will be signed a fellowship agreement in accordance with the model here
Fellowship holder Assessment: At the end of each period of duration of the fellowship contract, the activity developed by the fellowship holder will be evaluated by the supervisor, by applying the following criteria, in accordance with the model here.
Criteria 1 - Compliance with the activity plan (30%)
Criteria 2 – Technical and scientific performance (30%)
Criteria 3 – Development of scientific activity reports and knowledge transfer activities (30%)
Criteria 4 – Responsibility and assiduity (10%)
Supervisor report model here
Fellowship holder report:
By the end of each fellowship period the fellowship holder must present a report. You can find the fellowship holder final report model here
Disabled candidates shall be preferred in a situation of equal ranking, and said preference supersedes any legal preferences. Candidates must declare, on their honour, their respective disability degree, type of disability and communication / expression means to be used during selection period on their application form, under the regulations above.
CCMAR’s non-discrimination and equal access opportunities policy – No candidate can be privileged, benefited, jeopardised or be deprived of any right or exempt of any claim in regards to descendent, age, gender, sexual orientation, marital status, economic situation, origin, social economy, genetic heritage, disability, chronic disease, nationality, ethnicity, territory of origin, language, religion, politics, ideology or union membership.
Faro, February the 19th, 2025

